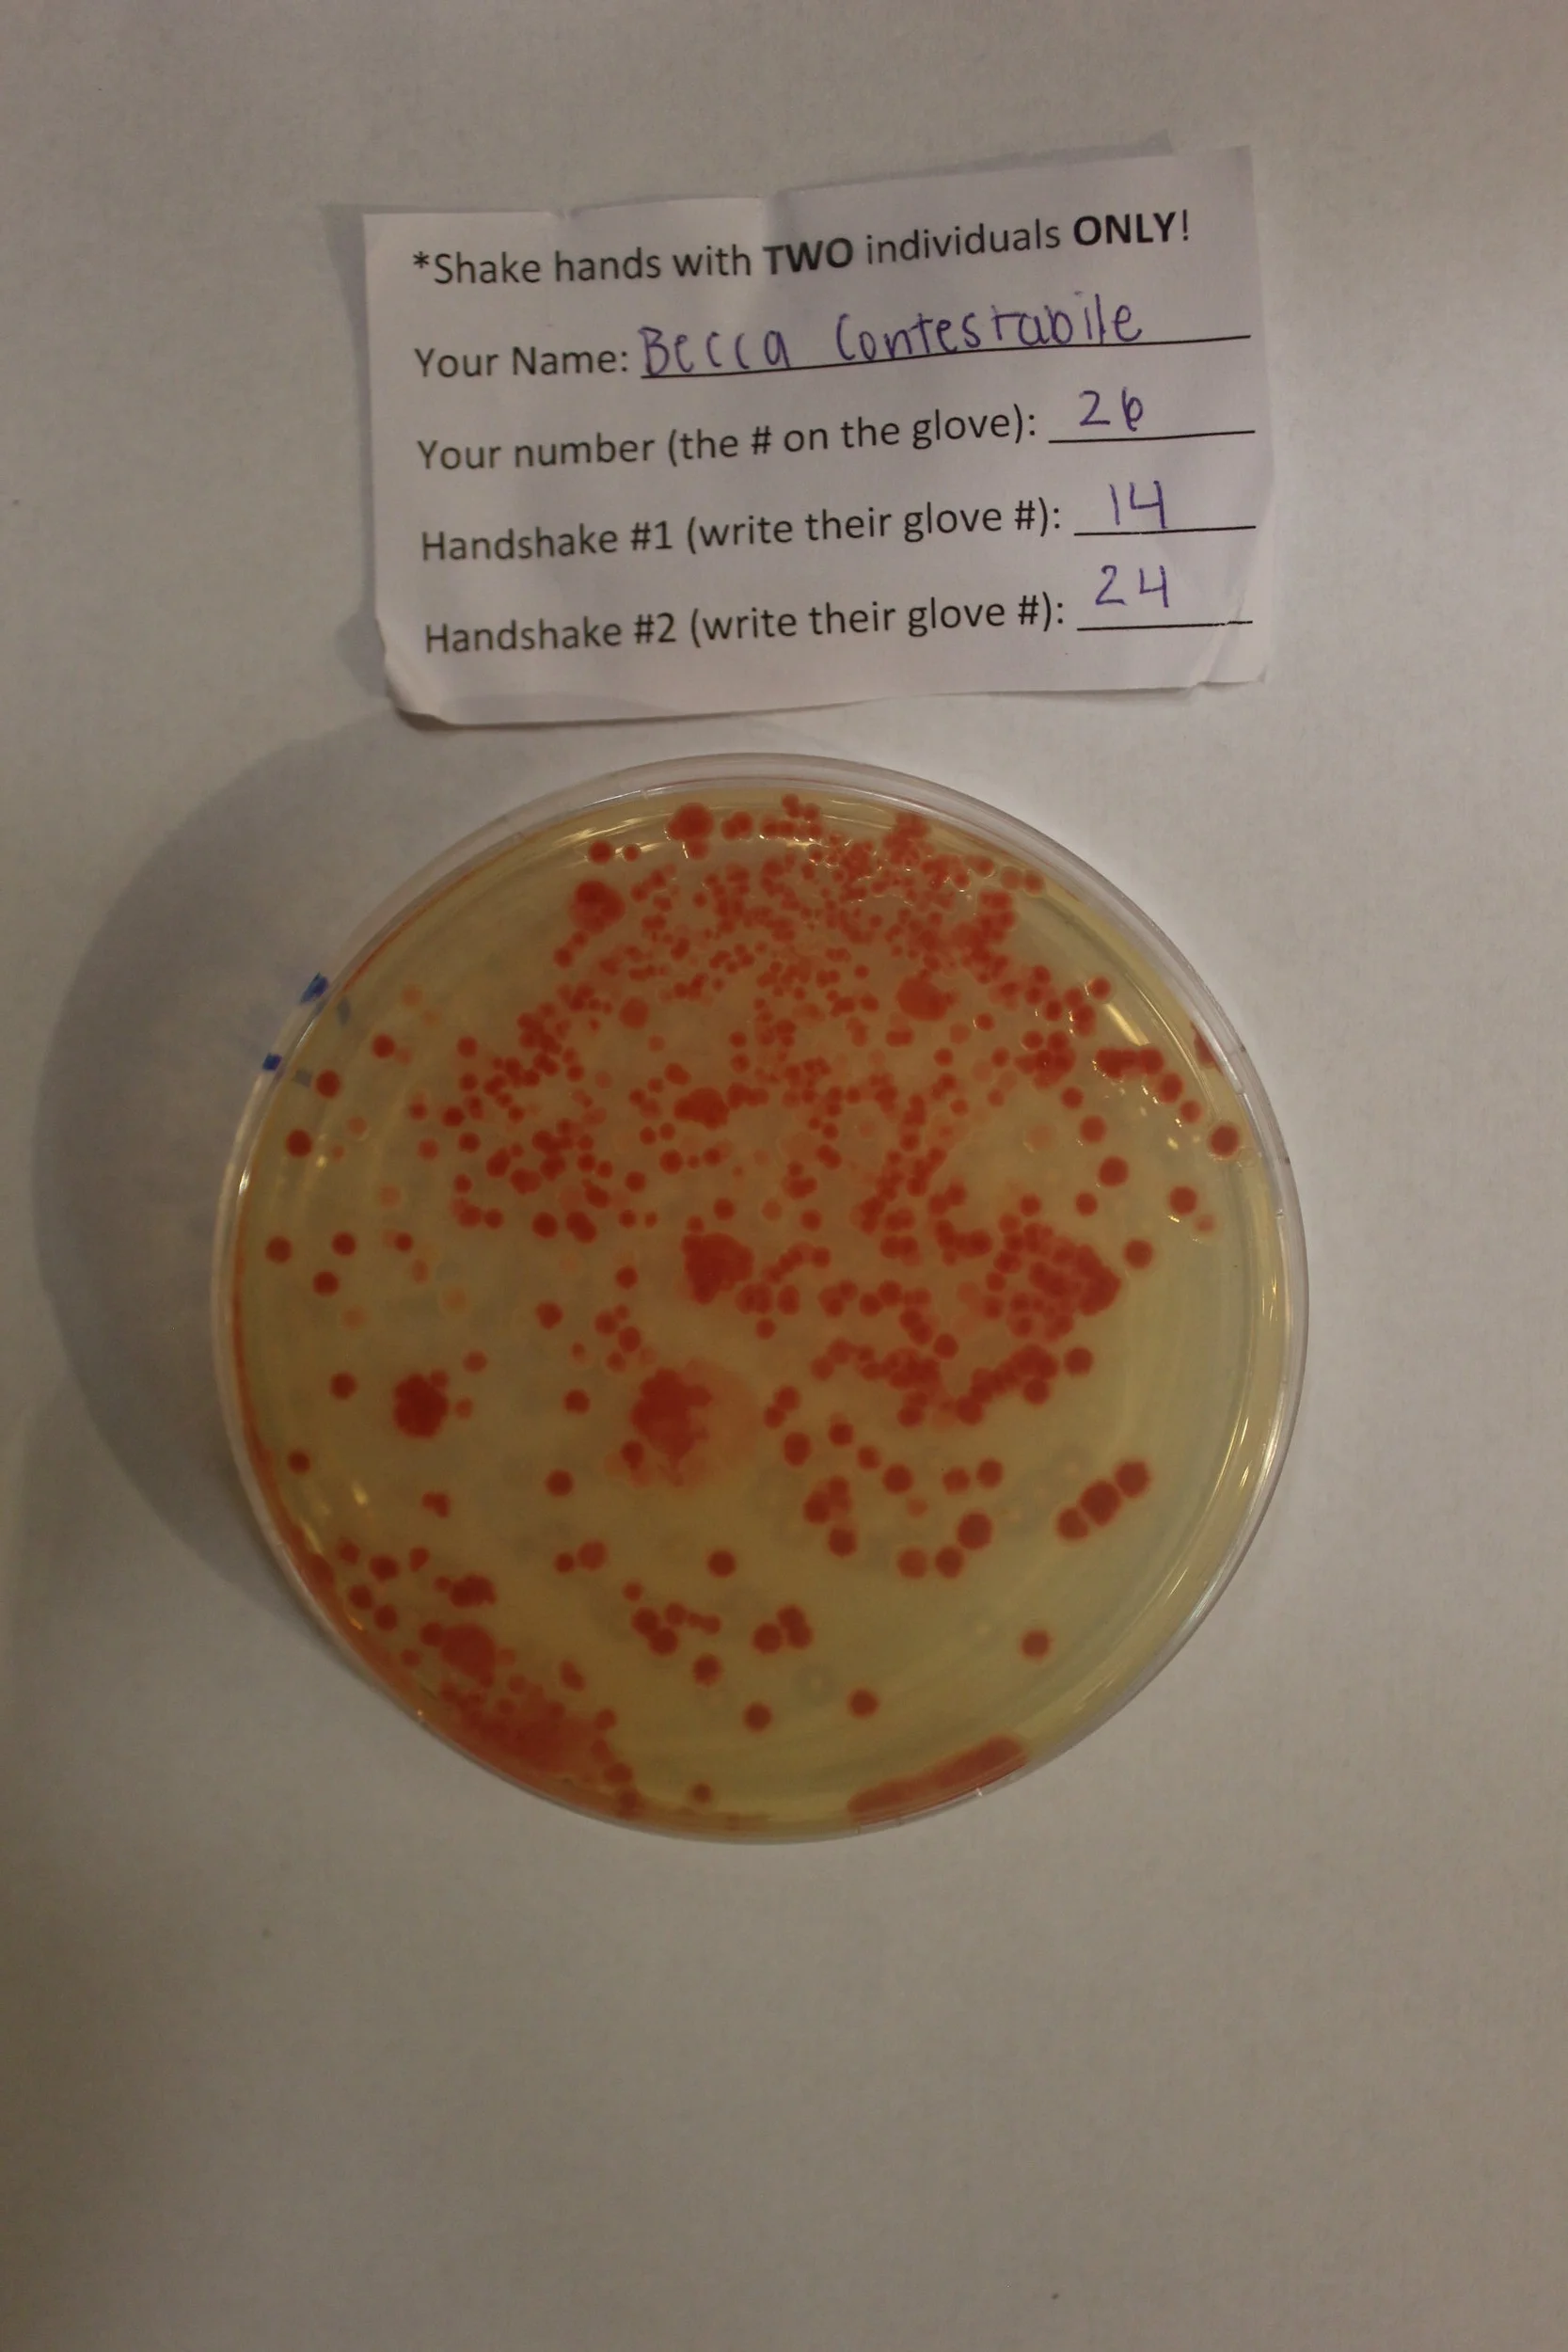
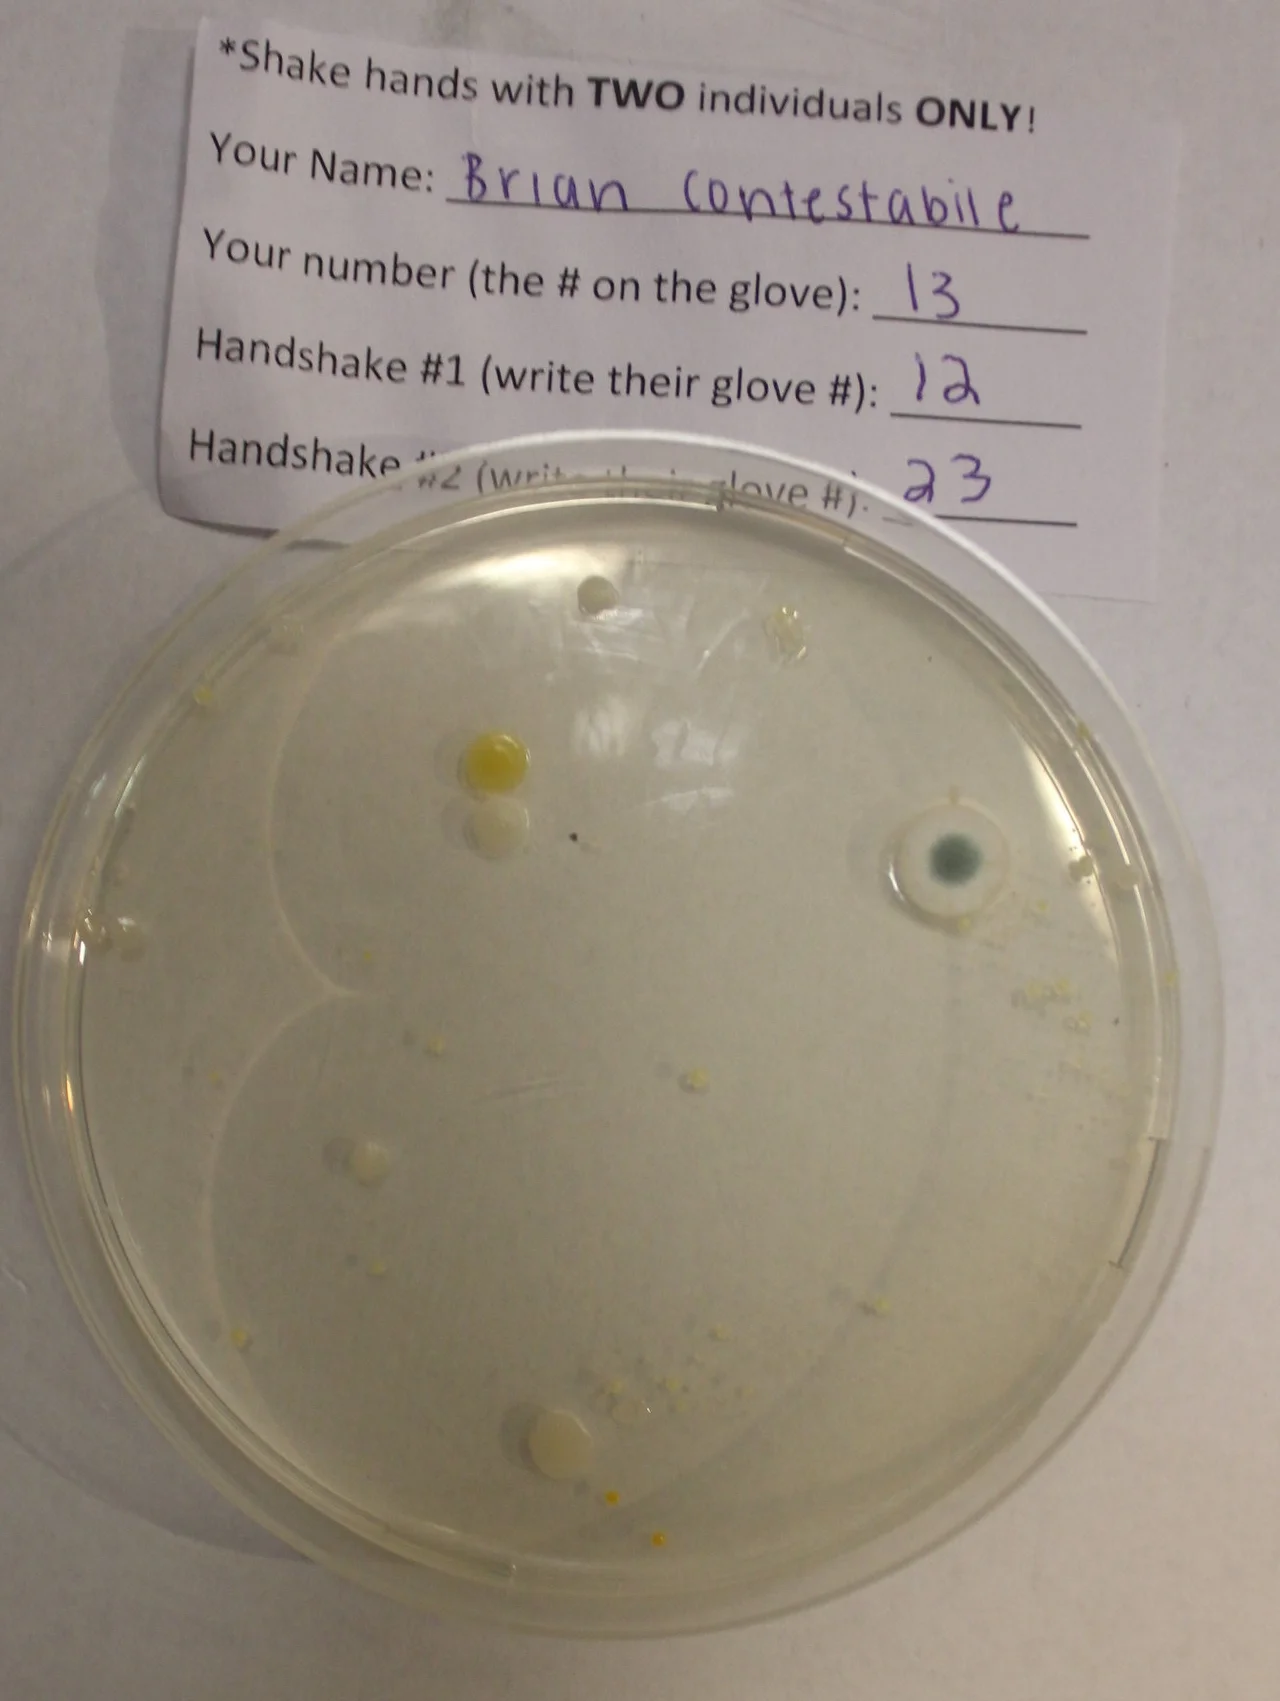

EPIDEMIOLOGY: DISEASE SPREAD SCIENCE
ARE YOU UP FOR THE CHALLENGE???
In the midst of the COVID-19 Pandemic and students AT HOME for the next few weeks we have a fun related challenge for anyone who wants to take a crack at it and learn a little about epidemiology and the spread of disease in the process.
Recently at a local university, we simulated the spread of an EPIDEMIC via a group of real people to spread a “disease” through the population via hand shaking. Contacts were made, hands were swabbed, bacteria was grown on petri dishes, and Photo results were recorded so now you can try to map the spread using the information below!
Use the information below to try to trace the spread by making a KEY/chart that leads us to Patient Zero.
NOTE: This is like real life in that it is a bit MESSY. Some people did not report shaking when they most likely did and others shook with 3 hands instead of 2. Pay attention to the details and see how far you can get. If you have a knack for this maybe you can help the CDC out when you grow up!
We Incubated petri dishes for 48-72 hrs so the bacteria would grow colonies big enough to see with the naked eye (they look like Magenta/Reddish/Pink dots). See photo results of each plate to make your key to determine the spread of the "disease" through people's handshakes.
What are we trying to determine from the results?
A: Who is patient zero (or candidates for patient zero), how did the bacteria (disease) spread, and who are the lucky ones? Use whatever resources you want. Make your own flow chart/key of the spread and submit to us via a FB message or to sara@outsidetheboxlabs.com by May 1st 2020 for a chance to have it posted with the final results for bragging rights. Anyone who correctly determines patient zero has a claim to fame :)
Want to take on the challenge but not sure you can do it alone, call up a friend and work on it together over the phone or via a share your screen chat app. Are you up for it?
Background FROM THE EXPERIMENT
We handed out a bunch of gloves coated in a bacterial growth broth medium (bacteria food in liquid form). All of the gloves were coated with broth so that no one would be able to tell if they had the glove that had the "infectious disease"(i.e. PATIENT ZERO) or not…only one individual actually received a glove that had broth contaminated with live bacteria. Everyone was to shake hands with two and ONLY two other people and record the numbers of who they shook with.
Therefore, when Patient Zero (the person who had the disease first) swabbed their plate from their own glove their results should show the highest # of bacteria (or highest # of bacterial colonies: Each pink dot on the plate is one colony) on their petri dish. If the plate has an extremely high amount of the bacteria you may not see individual "dots" or "colonies" but will simply see a streak/lines which is so many that it just forms together in what we call a "lawn" of growth. This is someone who was either patient zero or infected with a heavy amount at the beginning of the experiment.
Some people will have shaken with that person and then shaken with someone else, spreading the disease. Some may have been "lucky" and shaken with two people before the spread and may not have gotten infected. The less bacterial "colonies" a person has on their plate, the further removed they were from contact with Patient Zero.
*This bacteria grows pink/magenta so only pink colonies are counted (as other colonies could just be contaminants from other things that were already on the participants gloves). You DO NOT have to actually count all of the dots if you can visually tell that there are less than another plate combined with the knowledge of handshake order to determine the spread.
*Keep in mind that although people were only supposed to shake two hands, human error occurs. If something seems out of place, try to account for human error and move past it to make your KEY/CHART of the spread. Keep in mind it is also possible for someone that did not have growth on their plate to also spread it to others. Their swab technique could have been faulty, allowing them to avoid picking up the bacteria from their glove and transferring it to their plate. Keep this type of thing in mind when creating your chart! Good luck everyone!
THE Result Plates from All the participants in THIS CURRENT “SIMULATION OF AN EPIDEMIC Challenge” are in the photo gallery FOR YOU directly below:

Photo Results from OUR PRevious EPIDEMIC SIMULATION CHALLENGE are directly below in case you want to practice with this and see the result key to make sure you’ve got the idea before you start the one above!













Our Community Partners







